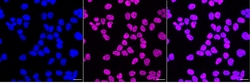
Invitrogen CtBP2 Recombinant Rabbit Monoclonal Antibody (23GB5120), Invitrogen

missing translation for 'onlineSavingsMsg'
Learn More
Learn More
Invitrogen™ CtBP2 Recombinant Rabbit Monoclonal Antibody (23GB5120), Invitrogen™
Rabbit Recombinant Monoclonal Antibody
Brand: Invitrogen™ MA553851
This item is not returnable.
View return policy
Description
This gene produces alternative transcripts encoding two distinct proteins. One protein is a transcriptional repressor, while the other isoform is a major component of specialized synapses known as synaptic ribbons. Both proteins contain a NAD+ binding domain similar to NAD+-dependent 2-hydroxyacid dehydrogenases. A portion of the 3' untranslated region was used to map this gene to chromosome 21q21. 3; however, it was noted that similar loci elsewhere in the genome are likely. Blast analysis shows that this gene is present on chromosome 10.
Specifications
| CtBP2 | |
| Recombinant Monoclonal | |
| Unconjugated | |
| CTBP2 | |
| AA407280; CTBP2; C-terminal binding protein 2; C-terminal-binding protein 2; D7Ertd45e; gene trap ROSA b-geo 6; Gtrgeo6; Ribeye; RP11-59C5.2 | |
| Rabbit | |
| Affinity chromatography | |
| RUO | |
| 13017, 1488, 81717 | |
| -20°C | |
| Liquid |
| Flow Cytometry, Western Blot, Immunocytochemistry | |
| 23GB5120 | |
| PBS with 50% glycerol and 0.02% sodium azide; pH 7.4 | |
| P56545, P56546, Q9EQH5 | |
| CTBP2 | |
| A synthesized peptide derived from human CTBP2 (415-445AA). | |
| 20 μL | |
| Primary | |
| Human, Mouse, Rat | |
| Antibody | |
| IgG |
Product Content Correction
Your input is important to us. Please complete this form to provide feedback related to the content on this product.
Product Title
Spot an opportunity for improvement?Share a Content Correction